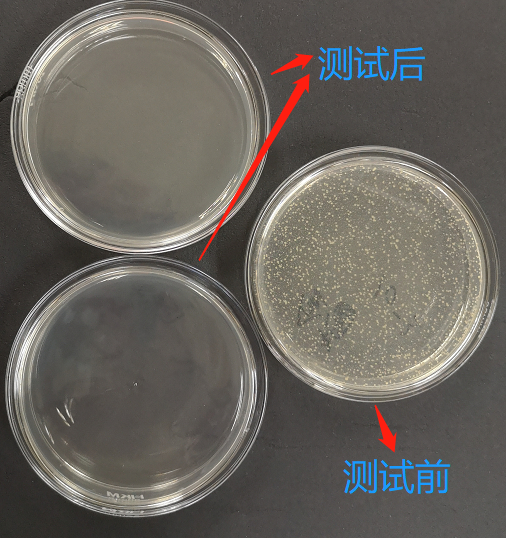

原标题:消毒湿巾专业测评结果出炉!最贵1.16元一片
来源:中国消费者报
疫情期间出行
必备的就是能随身携带的消毒湿巾
但跟酒精、消毒液相比
消毒湿巾能起到消毒的效果吗?
来看青海市消协和深圳消委会发布的
比较试验结果
👇

▲ 本次比较试验的15款样品,其中10款酒精湿巾、5款含杀菌有效成分的湿巾(不含酒精)。
综合星级评价
含杀菌有效成分湿巾(不含酒精)





含酒精湿巾





不予评价:





■ 杀菌性能良好
15款消毒湿巾样品在3个作用时间(30秒、1分钟、1分30秒)对4种测试细菌菌种(铜绿假单胞菌、白色念珠菌、大肠杆菌、金黄色葡萄球菌)的灭杀率均达到99.99 %。
▲ 消毒湿巾杀菌性能效果测试图
■ 酒精浓度参差不齐
10款含酒精的消毒湿巾样品中,有6款酒精浓度低于75 %(±5 %),最低的1款样品乙醇浓度仅有5.2 %。

▲ 10款含酒精消毒湿巾样品乙醇浓度%(V/V)
■ 化学安全性指标均达标
15款消毒湿巾样品甲醇含量测试结果为“未检出”、均通过MIT、CIT及甲醛防腐剂测试、均通过微生物测试。
■ 部分标识标签与实测值不符
有5款样品酒精浓度标称值与实测值不符,其中1款样品为三无产品。

▲ 酒精浓度标称值与实测值不相符样品详情
■ 价格:进口贵于国产
本次比较试验五星产品中,5款含酒精消毒湿巾的平均价格为0.34元/片,5款含杀菌有效成分(非酒精)消毒湿巾的平均价格为0.51元/片。其中,最贵的消毒湿巾是进口品牌日本花王biore除菌湿巾,价格为1.16元/片; 而同等级同类型的国内品牌心相印售价仅为0.28元/片。

▲ 10款五星评价消毒湿巾价格排列情况(元/片)
注:本次比较试验结果仅对所购买的样品负责,结果仅供消费者参考,不代表同品牌不同批次、不同规格产品的质量状况,不构成对相关产品的推荐与宣传。
消费提示
①不建议频繁使用。消毒湿巾中的杀菌有效成分(如酒精或季铵盐类)会刺激皮肤、黏膜及眼睛,频繁使用会破坏保护皮肤的皮脂膜,让皮肤变得干燥易得皮肤病。在使用消毒类产品后建议涂抹润肤产品,避免皮肤过于干燥。
②不建议使用酒精类消毒湿巾消毒伤口。根据深圳市慢性病防治中心介绍,一般医用酒精的浓度为75%,酒精刺激性强,用于伤口会产生强烈的剧痛感, 会影响伤口的愈合,存在破伤风感染的风险。
③建议选购中小包装或有独立包装的消毒湿巾。购买时要确认产品包装完好,无破损、漏气、漏液等现象,最好选购包装有密封贴的产品,并在购买前确认其是否在保质期内。
④使用酒精类消毒湿巾后应避免接触明火。浓度在60%以上的酒精遇火即燃,因此储存时和使用酒精类的消毒湿巾后,均应避免靠近或接触明火,以免发生意外。

⑤在外如需接触公共场所物品,应先使用消毒湿巾等产品擦拭后再接触,如来不及提前擦拭,应在接触后及时消毒,做好个人防护。


